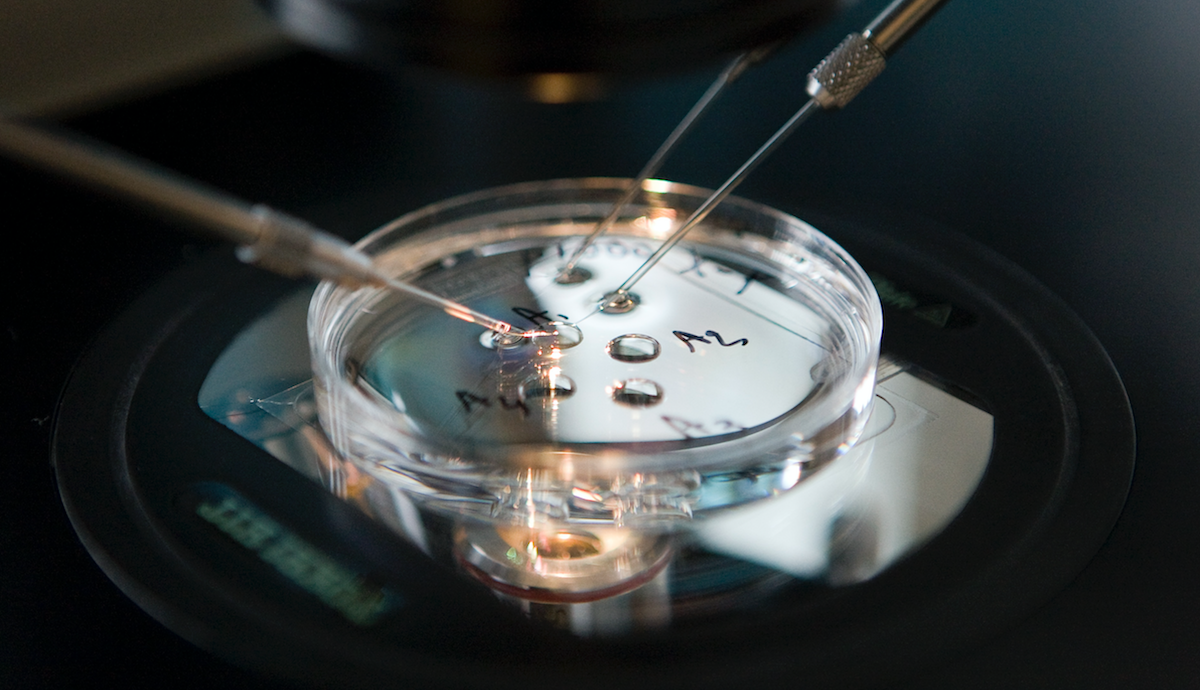

Dit is het ochtendnieuws van vrijdag 9 februari: ‘Stop met kinderen pushen naar hoogste schoolniveaus’, voor het eerst menselijke eicel buiten lichaam volgroeid en Gordon openhartig over drugsgebruik in biografie.
Wil je elke ochtend onze speciale selectie van het nieuws van de dag in je mailbox, meld je dan hier aan. Je begint je dag in ieder geval goed geïnformeerd.
Jehovah’s houden verslagen over kindermisbruik achter

In archieven zijn jarenlang verslagen bewaard van mogelijk honderden interne rechtszaken. Dat blijkt uit onderzoek van RTL Nieuws. Die interne rechtszaken liepen tegen Jehova’s die beschuldigd waren van seksueel kindermisbruik. Daarin staan details van de zaken en soms zelfs bekentenissen van daders, maar het is niet het beleid van de organisatie om die dossiers met de politie te delen. Slachtoffers hebben nu grote angst dat de documenten vernietigd worden en mogelijk bewijsmateriaal verloren gaat. Ze roepen Jehovah’s Getuigen op om de verslagen per direct te overhandigen aan het Openbaar Ministerie. Vooralsnog weigert Justitie de papieren op te eisen.
(RTL Nieuws)
‘Stop met kinderen pushen naar hoogste schoolniveaus’

De druk om beter te presteren leidt bij kinderen tot veel stress. Daarvoor waarschuwt minister Arie Slob. Het aantal vmbo-leerlingen daalt, met name op de laagste niveaus. Voor een deel komt dat door de bevolkingskrimp, maar een andere belangrijke reden is dat veel ouders hun kinderen liever niet naar het vmbo, maar naar een hoger niveau zien gaan. “Het vmbo is niet een soort vergaarbak van kinderen die niet naar havo of vwo kunnen, en dus maar naar het vmbo moeten. Dit is geen restonderwijs”, zegt hij in het AD. Volgens Slob heerst er een maatschappelijke tendens waarin het vmbo als ‘niet goed genoeg’ wordt gekwalificeerd. Daar moet een einde aan komen, vindt Slob, ook omdat vmbo’ers hard nodig zijn. “Een kind moet niet voortdurend druk ervaren omdat hij of zij het schoolniveau niet aankan.”
(AD)
Voor het eerst menselijke eicel buiten lichaam volgroeid
Deze doorbraak kan een grote stap zijn in onderzoek naar medicijnen en vruchtbaarheid. Dat schrijven de Britse en Amerikaanse wetenschappers vandaag in het medische tijdschrift Molecular Human Reproduction. Het volledig groeien van een eicel was hiervoor alleen nog maar gedaan met muizen. Dat ging zo goed dat er zelfs muizen werden geboren uit die eicellen. Menselijke eicellen waren wel eerder al buiten het lichaam gegroeid, maar niet vanaf het begin. Het is momenteel nog lang niet mogelijk om de eicellen ook te bevruchten, maar dat kan in de toekomst wel een optie worden. Dat zou voor mensen die een chemokuur moeten ondergaan een optie zijn om daarna alsnog kinderen te kunnen krijgen.
(Molecular Human Reproduction)
Feyenoord-spandoek valt verkeerd bij Groningers

‘We zullen ze laten beven!’, stond er in grote letters op te lezen. Dat zorgde voor flinke verontwaardiging bij FC Groningen, tegen wie de Rotterdammers gisteren in De Kuip speelden. Fox Sports tweette voor het begin van het eredivisieduel tussen Feyenoord en FC Groningen een foto van het spandoek. ‘Smakeloos!’, reageerde de Groningse voetbalclub vervolgens op Twitter. Met de tekst verwezen de supporters van Feyenoord waarschijnlijk naar de aardbevingsproblematiek die de noordelijke provincie al jaren teistert, maar de zin is ook een zin uit één van hun clubliederen, genaamd ‘Wat gaan we doen vandaag’.
(RTV Noord)
Gordon openhartig over drugsgebruik in biografie

In de eerste verschenen passages vertelt hij gedetailleerd over zijn problemen door drugs. “Dat geeft me een beter gevoel. Ik ben soms thuis alleen in mijn eentje coke aan het snuiven, puur om het kutgevoel uit mijn lijf te krijgen”, zegt hij in het boek, waarvan HP/DeTijd in het maartnummer enkele quotes heeft geplaatst. Ook vertelt hij over een angstaanjagend moment dat veroorzaakt werd door de drugs: “Ik stond onder de douche en dacht: ik heb teveel genomen, ik geloof dat ik 112 moet bellen. Ik had zoveel gesnoven dat ik er hartkloppingen van kreeg.” Vorig jaar augustus liet Gordon aan Privé al doorschemeren dat hij heftige onthullingen doet in de biografie. “Er zullen heel wat mensen steil achteroverslaan als mijn boek straks in de winkel ligt.” Gordons biografie verschijnt 28 februari.
(De Telegraaf)
Alwéér ophef over topless-foto Kim Kardashian

De foto is genomen door Kims oudste dochter, de vierjarige North. Hierop trekt Kim haar beha uit voor de spiegel en bedekt haar borsten met haar handen. North is via de spiegel te zien op de achtergrond. Veel volgers vinden het zeer ongepast dat de vierjarige is ingeschakeld voor een topless-foto van haar moeder. Eén van de bezoekers van haar profiel schrijft: ‘Het is raar en creepy dat je je kleine kind suggestieve foto’s van jezelf laat nemen terwijl je een heel team hebt dat dat ook hadden kunnen doen.’ Een andere volger plaatste in de comments: ‘Zou je het ook posten als ze een foto van Kanye maakte terwijl hij z’n boxershort uitdeed?’ Ondanks de veelal negatieve reacties, is de foto wel al bijna 2,3 miljoen keer geliket. Kim heeft niet gereageerd op het commentaar.
(ANP)
https://www.instagram.com/p/Be8V9RCFmMy














